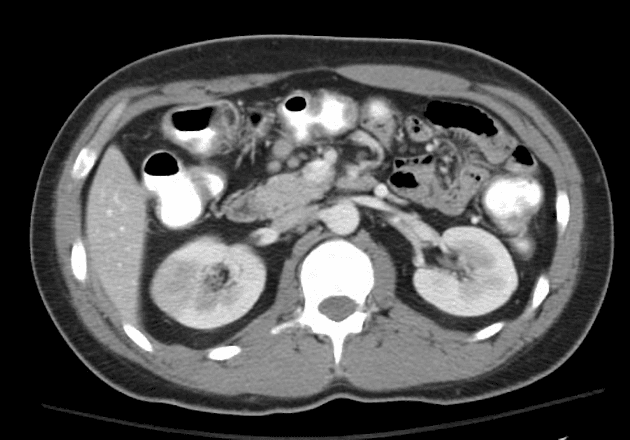
Renal Infarction Due to Renal Vein Thrombosis (Nhồi máu thận - huyết khối tĩnh mạch thận)

Thu, Apr 9
AI Trực tuyến
Series (4)
Axial low monoE

CT•Axial low monoE•1 / 175
Ca bệnhRuột bị thiếu máu do thoát vị nội tạng kèm theo thủng
Ruột bị thiếu máu do thoát vị nội tạng kèm theo thủng
Nguồn gốc
Dữ liệu bệnh nhân
Tuổi75 year
Giới tínhMale
Bệnh sử lâm sàng
Đau bụng tăng dần trong 3 ngày. Không đi tiêu được trong 2 ngày.
Chẩn đoán & Phát hiện
- Lượng dịch tự do và khí trong ổ bụng nhiều, cho thấy thủng tạng rỗng (perforated hollow viscus). Phần lớn khí tự do nằm ở vùng trên bên phải ổ bụng.
- Các quai ruột non ở phía bên phải ổ bụng giãn vừa, nằm kề sát và trước đại tràng lên và manh tràng.
- Các quai ruột này cho thấy giảm rõ rệt tăng quang thành ruột (markedly reduced mural enhancement) (rõ nhất trên tái tạo low monoE), hình ảnh này gợi ý thiếu máu ruột (bowel ischemia).
- Động mạch mạc treo tràng trên (SMA), tĩnh mạch mạc treo tràng trên (SMV) và tĩnh mạch cửa (portal vein) thông thoáng (patent).
- Các nhánh động mạch mạc treo tràng trên cung cấp máu cho vùng này được cản quang kém.
- Dựa vào phân bố các quai ruột bị tổn thương, thoát vị nội tạng (internal hernia) được nghi ngờ.
- Ống thông tiểu nằm trong bàng quang (bladder).
- Gan, lách, tuyến thượng thận (adrenal gland), tụy và thận có hình ảnh bình thường.
- Ghi nhận thoát vị bẹn trực tiếp (direct inguinal hernias) nhỏ hai bên.
- Tràn dịch màng phổi (pleural effusion) hai bên mức độ nhẹ kèm theo xẹp phổi (atelectasis) vùng đáy.
- Ghi nhận các tổn thương nén dẹp bản tiếp hợp (endplate compression injury) và nốt Schmorl mang tính mạn tính (chronic) ở cột sống thắt lưng. Không thấy hình ảnh gãy xương cấp tính (acute fracture) hay tổn thương xương bất thường. Một vài gãy xương sườn cũ được ghi nhận ở vùng trước bên phải.
- Có bằng chứng của thủng tạng rỗng (perforated hollow viscus), nguồn gốc có khả năng nhất là các quai ruột ở vùng bụng phải trước có hình ảnh thiếu máu (ischemic). Nguyên nhân cơ bản chưa rõ, thoát vị nội tạng (internal hernia) là một khả năng (qua mạc treo – trans mesenteric).
DISCUSSION:
Bệnh nhân được đưa ngay vào phòng mổ để thực hiện mổ bụng (laparotomy).
Tìm thấy khi mổ (Operative findings):
- Thoát vị nội tạng (internal hernia) kèm theo hồi cuối ruột non (distal ileum) rõ ràng bị thiếu máu (ischemic).
- Ghi nhận nhiều dải mạc nối (omental bands).
- Dịch huyết mủ (haemopurulent fluid) trong cả 4 vùng bụng.
Thủ thuật (Procedure):
- Phát hiện và cắt các dính dải mạc nối (omental band adhesions).
- Giảm thoát vị nội tạng (internal hernia).
- Khoảng 30cm hồi cuối ruột non (distal ileum) bị thiếu máu và hoại thư (ischemic and gangrenous).
- Cắt ruột ở đoạn trên và dưới vùng ranh giới bằng dụng cụ 80GIA.
- Rửa ổ bụng bằng nước muối sinh lý (saline) với lượng lớn.
- Tạo dịch vị hồi tràng kiểu Abcarian (abcarian ileostomy).
- Đặt dẫn lưu ở vùng chậu và rãnh cạnh đại tràng phải.
- Khâu da bằng chỉ PDS và kẹp staples.
Chẩn đoán
Thiếu máu ruột do thoát vị nội tạng kèm theo thủng (Ischemic bowel due to internal hernia with perforation)
Chẩn đoán phân biệt
- 1.Thiếu máu mạc treo do tắc động mạch mạc treo tràng trên
- 2.Tắc ruột non kèm nghẹt
- 3.Loét tiêu hóa thủng
Điểm giảng dạy
- "Thiếu máu ruột không do tắc nghẽn có thể không kèm giãn quai ruột, làm cho dấu hiệu giảm tăng quang thành ruột trở thành manh mối hình ảnh quan trọng."
- "Thoát vị nội tạng có thể không rõ ràng trên CT và cần đánh giá cẩn thận phân bố ruột và tưới máu mạch máu."
- "Khí tự do ở vùng thượng vị phải liền kề quai ruột thiếu máu gợi ý thủng như một biến chứng của tình trạng thiếu máu ruột."
Thảo luận
Thiếu máu ruột do thoát vị nội tạng là một cấp cứu ngoại khoa. Thoát vị nội tạng xảy ra khi một đoạn ruột lồi qua một khuyết tật bẩm sinh hoặc mắc phải ở mạc treo, phúc mạc hoặc mạc đại tràng. Trường hợp này cho thấy các dấu hiệu hình ảnh quan trọng: thiếu máu ruột không tắc nghẽn với giảm tăng quang thành ruột dù động mạch và tĩnh mạch mạc treo tràng trên vẫn thông thoáng, gợi ý tưới máu ngoại vi bị tổn hại. Sự hiện diện của khí và dịch tự do xác nhận tình trạng thủng, một biến chứng đe dọa tính mạng. Can thiệp phẫu thuật sớm là thiết yếu, vì chẩn đoán muộn dẫn đến hoại tử, nhiễm trùng huyết và tỷ lệ tử vong cao. Trong mổ, việc giảm thoát vị, cắt đoạn ruột không còn sống và ly giải dính là các bước quan trọng. Trường hợp này nhấn mạnh tầm quan trọng của việc nhận biết các dấu hiệu CT tinh tế của thoát vị nội và thiếu máu ruột, ngay cả khi không có tắc nghẽn rõ ràng.